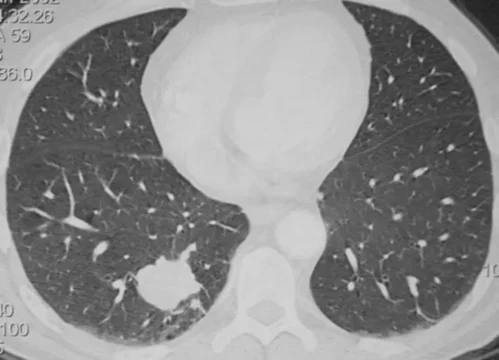
Nodule pulmonaire

Tout savoir à propos de l’offre de soins
Pneumologie, Oncologie Thoracique, Allergologie et Soins Intensifs Respiratoires
Pneumologie générale
Pathologies
Bronchopneumopathie chronique obstructive (BPCO)
Insuffisance respiratoire
Pathologies pleurales (pneumothorax, pleurésies)
Symptômes respiratoires chroniques (toux chronique, dyspnée)
Médecins
Dr R. Barnestein
Dr J. Benzaquen
Dr J. Boutros
Dr M. Delin
Dr B. Gerard
Dr E. Hazouard
Dr C. Ichim Noghi
Dr S. Karam
Pr S. Leroy
Pr C. Marquette
Dr J. Pradelli
Immuno-allergologie et allergies graves
Tests cutanees allergiques, Mesure du souffle, Etude de la fonction respiratoire
Pathologies
Asthme, rhinite
Allergies graves (allergies alimentaires, médicamenteuses et venins d’hyménoptères)
Allergie aux anesthésiques et produits de contraste
Médecins
Dr E. Aguinet
Dr M. Ben Hayoun
Dr M. Delin
Pr S. Leroy
Dr I. Petit
Dr J. Pradelli
Dr G. Rezzadori
Cancérologie thoracique
Pathologies
Cancers du poumon, de la plèvre et du médiastin
Médecins
Dr J. Benzaquen
Dr J. Boutros
Pr C. Marquette
Pathologies respiratoires du sommeil et insuffisance respiratoire chronique
Médecins
Dr E. Hazouard
Dr C. Ichim Noghi
Dr S. Karam
Soins intensifs respiratoires
Médecins
Dr E. Hazouard
Dr R. Barnestein
Explorations fonctionnelles respiratoires au repos et à l'effort (EFX)
Spirométrie
Médecins
Dr M. Delin
Pr S. Leroy
Endoscopie respiratoire diagnostique et interventionnelle
Médecins
Dr J. Boutros
Dr J. Benzaquen
Pr C. Marquette
Aide au sevrage tabagique
Mucoviscidose - Centre de compétences
Médecins
Dr M. Delin
Pr S. Leroy
Centre de réhabilitation respiratoire et d’éducation thérapeutique ambulatoire
Unité de recherche clinique
Ingénieurs
Mme F. Amamou
Mme J. Griffonnet (coordinatrice)
Mme A. Gire
Mme R. Guettache
Mme A. Gora
Mme L. Philibert
Mme R. Poiron
Équipe d’encadrement des unités de pneumologie
Consultations